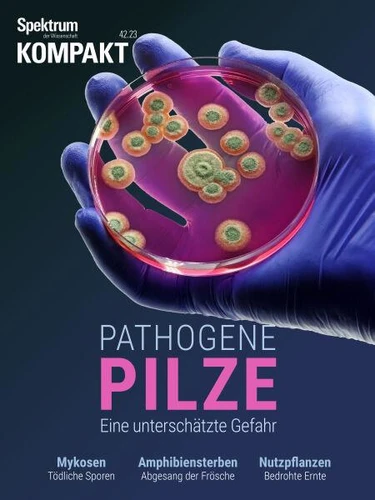

OFFRE LISEUSES
Une liseuse achetée = une housse offerte* jusqu'au 21 juin
Spektrum Kompakt - Pathogene Pilze. Eine unterschätzte Gefahr
Par :Formats :
Disponible dans votre compte client Decitre ou Furet du Nord dès validation de votre commande. Le format PDF protégé est :
- Compatible avec une lecture sur My Vivlio (smartphone, tablette, ordinateur)
- Compatible avec une lecture sur liseuses Vivlio
- Pour les liseuses autres que Vivlio, vous devez utiliser le logiciel Adobe Digital Edition. Non compatible avec la lecture sur les liseuses Kindle, Remarkable et Sony
- Non compatible avec un achat hors France métropolitaine
 , qui est-ce ?
, qui est-ce ?Notre partenaire de plateforme de lecture numérique où vous retrouverez l'ensemble de vos ebooks gratuitement
Pour en savoir plus sur nos ebooks, consultez notre aide en ligne ici
- Nombre de pages89
- FormatPDF
- ISBN978-3-95892-903-6
- EAN9783958929036
- Date de parution10/11/2023
- Protection num.Adobe DRM
- Taille15 Mo
- Infos supplémentairespdf
- ÉditeurSpektrum der Wissenschaft
Résumé
Bei gefährlichen Pilzen denken viele wohl zuerst an Fliegenpilz, Knollenblätterpilz und andere Giftpilze. Ein deutlich größeres Risiko geht allerdings von eher unscheinbaren Arten aus, die ständig in unserem Umfeld lauern. Teils sind sie so klein, dass wir sie mit dem bloßen Auge gar nicht sehen. Dennoch können sie uns und andere Lebewesen mitunter todkrank machen; manche raffen sogar ganze Tierpopulationen dahin.
Andere sind zwar sichtbar. Doch sobald sie sich zeigen, ist es für er-krankte Organismen meist schon zu spät - dazu zählen etwa solche, die massenhaft Nutzpflanzen vernichten. Diese Spektrum-Kompakt-Ausgabe fasst zusammen, welche tödlichen Bedrohungen im Reich der Pilze lauern.
Andere sind zwar sichtbar. Doch sobald sie sich zeigen, ist es für er-krankte Organismen meist schon zu spät - dazu zählen etwa solche, die massenhaft Nutzpflanzen vernichten. Diese Spektrum-Kompakt-Ausgabe fasst zusammen, welche tödlichen Bedrohungen im Reich der Pilze lauern.